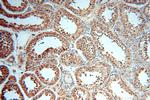
APOBEC4 Antibody in Immunohistochemistry (Paraffin) (IHC (P))

Search
Proteintech
APOBEC4 Polyclonal Antibody
{{$productOrderCtrl.translations['antibody.pdp.commerceCard.promotion.promotions']}}
{{$productOrderCtrl.translations['antibody.pdp.commerceCard.promotion.viewpromo']}}
{{$productOrderCtrl.translations['antibody.pdp.commerceCard.promotion.promocode']}}: {{promo.promoCode}} {{promo.promoTitle}} {{promo.promoDescription}}. {{$productOrderCtrl.translations['antibody.pdp.commerceCard.promotion.learnmore']}}
产品信息
17166-1-AP
种属反应
宿主/亚型
分类
类型
抗原
偶联物
形式
浓度
规格
纯化类型
保存液
内含物
保存条件
运输条件
产品详细信息
Immunogen sequence: MEPIYEEYL ANHGTIVKPY YWLSFSLDCS NCPYHIRTGE EARVSLTEFC QIFGFPYGTT FPQTKHLTFY ELKTSSGSLV QKGHASSCTG NYIHPESMLF EMNGYLDSAI YNNDSIRHII LYSNNSPCNE ANHCCISKMY NFLITYPGIT LSIYFSQLYH TEMDFPASAW NREALRSLAS LWPRVVLSPI SGGIWHSVLH SFISGVSGSH VFQPILTGRA LADRHNAYEI NAITGVKPYF TDVLLQTKRN PNTKAQEALE SYPLNNAFPG QFFQMPSGQL QPNLPPDLRA PVVFVLVPLR DLPPMHMGQN PNKPRNIVRH LNMPQMSFQE TKDLGRLPTG RSVEIVEITE QFASSKEADE KKKKKGKK (1-367 aa encoded by BC021711)
靶标信息
This gene encodes a member of the AID/APOBEC family of polynucleotide (deoxy)cytidine deaminases, which convert cytidine to uridine. Other AID/APOBEC family members are involved in mRNA editing, somatic hypermutation and recombination of immunoglobulin genes, and innate immunity to retroviral infection.
仅用于科研。不用于诊断过程。未经明确授权不得转售。
篇参考文献 (0)
生物信息学
蛋白别名: apolipoprotein B mRNA editing enzyme, catalytic polypeptide-like 4 (putative); Apolipoprotein B mRNA-editing enzyme catalytic polypeptide-like 4; Putative deaminase APOBEC-4; unnamed protein product
基因别名: APOBEC4; C1orf169
UniProt ID: (Human) Q8WW27
Entrez Gene ID: (Human) 403314